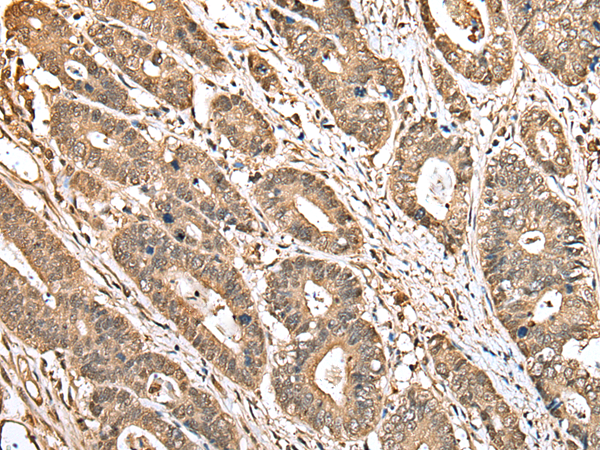

|
Background: |
The product of this gene is one of four proteins (cofactors A, D, E, and C) involved in the pathway leading to correctly folded beta-tubulin from folding intermediates. Cofactors A and D are believed to play a role in capturing and stabilizing beta-tubulin intermediates in a quasi-native confirmation. Cofactor E binds to the cofactor D/beta-tubulin complex; interaction with cofactor C then causes the release of beta-tubulin polypeptides that are committed to the native state. |
|
Applications: |
ELISA, WB, IHC |
|
Name of antibody: |
TBCA |
|
Immunogen: |
Full length fusion protein |
|
Full name: |
tubulin folding cofactor A |
|
SwissProt: |
O75347 |
|
ELISA Recommended dilution: |
5000-10000 |
|
IHC positive control: |
Human gastric cancer and human thyroid cancer |
|
IHC Recommend dilution: |
25-100 |
|
WB Predicted band size: |
13 kDa |
|
WB Positive control: |
Mouse adrenal gland tissue |
|
WB Recommended dilution: |
200-1000 |

購(gòu)物車
幫助
021-54845833/15800441009
